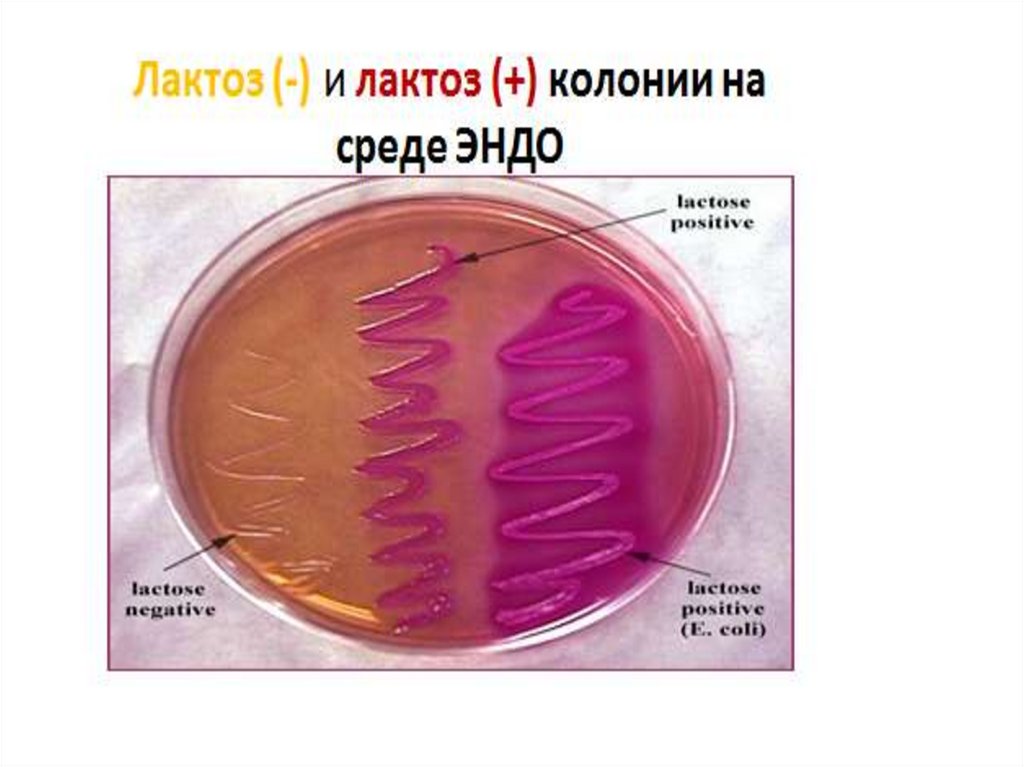

Похожие презентации:
Характеристика и классификация сальмонелл
1. ПЛАН
1. Характеристика и классификациясальмонелл.
2. Сальмонеллы – возбудители брюшного
тифа и паратифов. Свойства, патогенез,
клиника и лабораторная диагностика.
3. Сальмонеллы – возбудители
гастроэнтроколитов.

Биология
Биология








